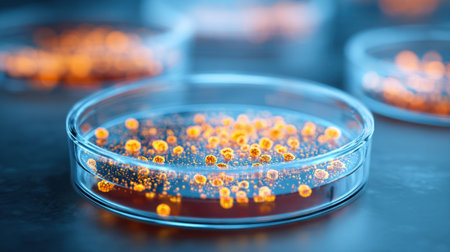
A close-up view shows petri dishes filled with a gelatinous medium where orange bacterial colonies are growing. This scene highlights research activities in a science lab setting.の素材

素材 - A close-up view shows petri dishes filled with a gelatinous medium where orange bacterial colonies are growing. This scene highlights research activities in a science lab setting.
作品情報
A close-up view shows petri dishes filled with a gelatinous medium where orange bacterial colonies are growing. This scene highlights research activities in a science lab setting.
- ID:260174215
- 作品種別:
- 作者名:formoney
キーワード
- academic
- analysis
- bacteria
- biology
- cell culture
- cell division
- colonies
- culture
- data collection
- education
- educational environment
- environmental
- equipment
- experiment
- experiments
- gelatinous medium
- genetics
- growth
- health sciences
- healthcare
- innovation
- isolate
- laboratory
- laboratory techniques
- microbiological analysis
- microbiology
- observation
- orange
- petri dish
- research
- research methods
- science
- scientific study
- specimen collection
- specimens
- sterile
- study
- university
類似作品
Camera lens wit...
Panoramic teles...
A stunning suns...
Morning mountai...
An Italian beau...
Beautiful view ...
A stunning refl...
Sunglasses refl...
Close-up of a c...
Close up of a t...
A view through ...
location mobile...
A close-up view...
Travel and adve...
A security came...
Aerial view of ...
A professional ...
A circular mirr...
Girl taking pic...
Abstract circul...
Coin operated b...
A crystal ball,...
Feet in white s...
Lisbon orange r...
Urban skyline m...
A blank wooden ...
moment of an an...
A photographers...
Sunglasses refl...
A detailed macr...
A hand holds a ...
A single, perfe...
human hands hol...
Bokeh of lights...
eye girl closeu...
A hand holding ...
Young woman tak...
Macro shot of y...
A detailed clos...
Panoramic view ...
Closeup human e...
earth view thro...
Bokeh city ligh...
Man is making p...
A detailed macr...
A camera on a t...
Vibrant citysca...